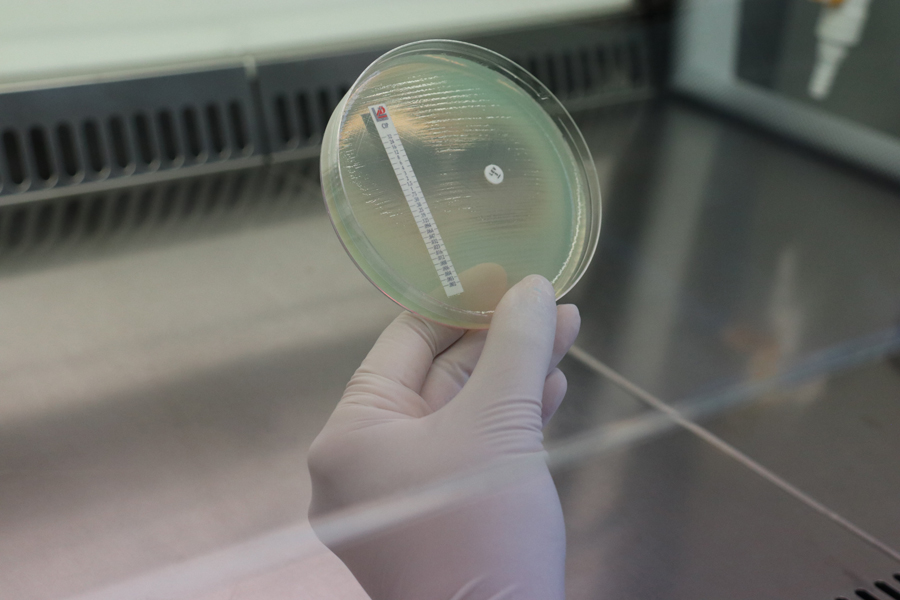
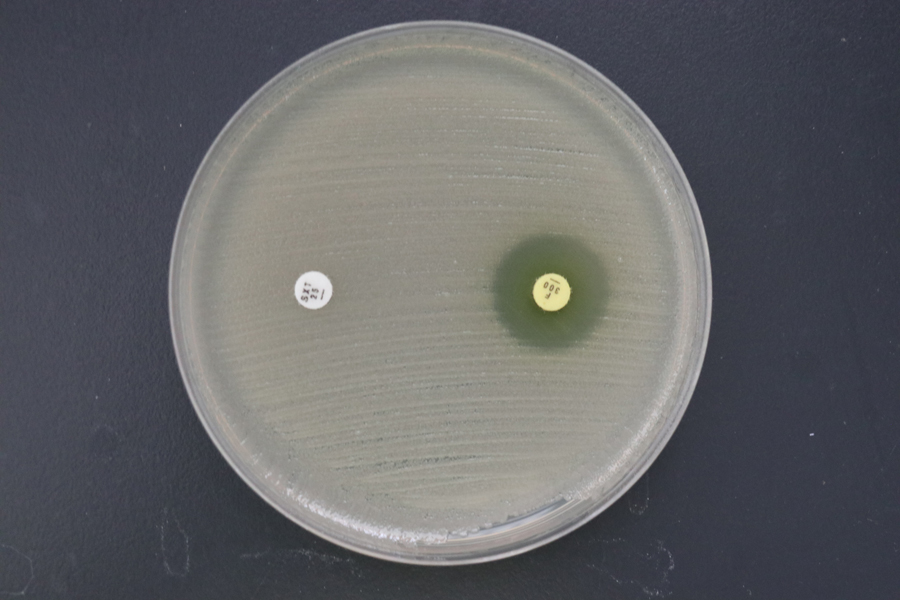

นายแพทย์บัลลังก์ อุปพงษ์ รองอธิบดีกรมวิทยาศาสตร์การแพทย์ เปิดเผยว่า ปัญหาเชื้อแบคทีเรียก่อโรคในคนมีแนวโน้มดื้อยาต้านจุลชีพอย่างต่อเนื่อง หรือที่เรียกว่าเชื้อดื้อยา (Antimicrobial Resistance; AMR) ส่งผลให้โรคติดต่อต่างๆ ที่เคยควบคุมได้กลับมาระบาด ทำให้มีค่าใช้จ่ายในการรักษาโรคติดเชื้อเพิ่มขึ้น สาเหตุสำคัญเกิดจากการใช้ยาต้านจุลชีพอย่างไม่เหมาะสม โดยการดื้อยาต้านจุลชีพเป็นสาเหตุสำคัญของการเสียชีวิต ในปี 2562 มีผู้เสียชีวิต 4.95 ล้านคนที่เกี่ยวข้องกับการดื้อยาต้านจุลชีพ โดย 1.27 ล้านคนเสียชีวิตโดยตรงจากการติดเชื้อแบคทีเรียดื้อยา ซึ่งร้อยละ 20 เป็นเด็กอายุต่ำกว่า 5 ปี หากไม่มีการจัดการที่จริงจัง คาดว่าการดื้อยาต้าน จุลชีพจะทำให้อายุขัยเฉลี่ยของประชากรโลกลดลง 1.8 ปีภายในปี 2568 และจำนวนผู้เสียชีวิตสะสมระหว่างปี 2568 – 2593 อาจสูงถึง 39 ล้านคน

สำหรับประเทศไทย งานวิจัยจากวารสารการวิจัยระบบสาธารณสุข เผยให้เห็นถึงสถานการณ์การดื้อยาต้านจุลชีพที่น่ากังวล โดยในปี 2553 มีรายงานว่าประเทศไทยมีผู้ติดเชื้อดื้อยาต้านจุลชีพประมาณ 88,000 คนต่อปี และในจำนวนนี้มีผู้เสียชีวิตจากการติดเชื้อดื้อยาสูงถึง 38,000 คน ส่งผลให้ผู้ป่วยต้องนอนโรงพยาบาลนานขึ้น 3.24 ล้านวันต่อปี คิดเป็นความสูญเสียทางเศรษฐกิจประมาณ 40,000 ล้านบาทต่อปี สถานการณ์เชื้อดื้อยาต้าน จุลชีพและการใช้ยาต้านจุลชีพในมนุษย์ พบว่าเชื้อ CRAB (Carbapenem-resistant Acinetobacter baumannii) เป็นสาเหตุสำคัญของการเสียชีวิตในโรงพยาบาล โดยในปี 2564 มีอัตราการดื้อยาสูงถึงร้อยละ 75.8 และ เชื้อ CRE (Carbapenem-resistant Enterobacteriaceae) เป็นสาเหตุสำคัญของการเสียชีวิตเช่นกัน โดยระหว่างปี 2560-2564 อัตราการดื้อยาเพิ่มขึ้นอย่างรวดเร็วจากร้อยละ 9.2 เป็นร้อยละ 15.2


นายแพทย์บัลลังก์ ได้เน้นย้ำอีกว่า การตรวจวินิจฉัยเชื้อทางห้องปฏิบัติการเป็นองค์ประกอบที่สำคัญของการเฝ้าระวัง ป้องกัน และควบคุมโรคจากเชื้อดื้อยา ดังนั้น กรมวิทยาศาสตร์การแพทย์ โดยสถาบันวิจัยวิทยาศาสตร์สาธารณสุข จึงจัดการอบรมเชิงปฏิบัติการเรื่อง “การพัฒนาสมรรถนะห้องปฏิบัติการเครือข่ายและระบบเฝ้าระวังเชื้อดื้อยาต้านจุลชีพ” เพื่อพัฒนาสมรรถนะด้านการตรวจวินิจฉัยเชื้อดื้อยาของห้องปฏิบัติการจุลชีววิทยาคลินิก ทบทวนความรู้เรื่องเชื้อดื้อยาให้เป็นปัจจุบัน ช่วยเพิ่มความเชื่อมั่นให้แพทย์นำข้อมูลไปใช้วางแผนการรักษาโรค และสนับสนุนกิจกรรมการป้องกันและควบคุมเชื้อดื้อยา รวมทั้งการใช้ยาอย่างเหมาะสม ชี้แจงรายละเอียดในแผนปฏิบัติการด้านการดื้อยาต้านจุลชีพแห่งชาติ ฉบับที่ 2 พ.ศ.2570 ตลอดจนระบบการเฝ้าระวังเชื้อดื้อยาแบบบูรณาการภายใต้แนวคิดสุขภาพหนึ่งเดียว โดยได้รับเกียรติจากวิทยากรจากหลายสถาบัน ประกอบด้วย กรมวิทยาศาสตร์การแพทย์ สำนักงานคณะกรรมการอาหารและยา กรมควบคุมโรค สำนักงานปลัดกระทรวงสาธารณสุข และวิทยากรจากมหาวิทยาลัย โดยผู้เข้ารับการอบรมประกอบด้วยนักเทคนิคการแพทย์ นักวิทยาศาสตร์การแพทย์ และเจ้าพนักงานวิทยาศาสตร์การแพทย์จากโรงพยาบาลและศูนย์วิทยาศาสตร์การแพทย์ เมื่อวันที่ 3-5 มีนาคม 2568 อบรมทั้งออนไซต์และออนไลน์กว่า 300 คน เพื่อเป็นประโยชน์ต่อการเฝ้าระวังเชื้อดื้อยาต้านจุลชีพของประเทศไทย